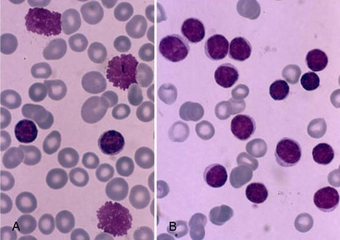
Kronik Lenfositik Lösemi Belirtileri ve Tedavisi

Kronik Kabızlık Belirtileri ve Tedavisi
Kronik kabızlık, sindirim sistemi rahatsızlıkları arasında sık görülen bir durumdur. Belirtileri arasında tuvalet sıklığında azalma, zorlanma ve karın ağrısı yer alır. Tedavi yöntemleri, diyet değişiklikleri, sıvı alımının artırılması ve fiziksel aktiviteyi kapsar. Sağlıklı yaşam tarzı benimsemek önemlidir.
Kronik Kabızlık Belirtileri ve Tedavisi Kronik kabızlık, bağırsak hareketlerinin düzensizliği ve zorlanması ile karakterize edilen bir sindirim sistemi rahatsızlığıdır. Bu durum, bireylerin yaşam kalitesini önemli ölçüde etkileyebilir ve uzun süreli sağlık sorunlarına yol açabilir. İşte kronik kabızlık ile ilgili temel bilgiler, belirtiler ve tedavi yöntemleri. Kronik Kabızlığın Belirtileri Kronik kabızlık belirtileri, bireyden bireye değişiklik gösterebilir. Genel olarak, aşağıdaki semptomlar gözlemlenmektedir:
Bunların yanı sıra, psikolojik durumlar da kabızlığı etkileyebilir. Stres, anksiyete ve depresyon gibi durumlar, bağırsak hareketlerini olumsuz yönde etkileyebilir. Kronik Kabızlığın Nedenleri Kronik kabızlığın birçok nedeni bulunmaktadır:
Kronik Kabızlığın Tanısı Kronik kabızlık tanısı, genellikle hastanın tıbbi öyküsü ve fiziksel muayene ile konulmaktadır. Doktor, belirtileri değerlendirir ve gerekirse ek testler isteyebilir. Bu testler arasında kan tahlilleri, dışkı analizi veya kolonoskopi yer alabilir. Kronik Kabızlığın Tedavi Yöntemleri Kronik kabızlık tedavisi, altta yatan nedene bağlı olarak değişiklik gösterebilir. Genel olarak aşağıdaki yöntemler uygulanabilir:
Sonuç Kronik kabızlık, yaşam kalitesini olumsuz etkileyen yaygın bir durumdur. Belirtilerinin ciddiye alınması ve uygun tedavi yöntemlerinin uygulanması önemlidir. Bireylerin, sağlıklı bir yaşam tarzı benimsemeleri ve düzenli sağlık kontrolleri yaptırmaları önerilmektedir. Eğer kabızlık belirtileri uzun süre devam ederse, mutlaka bir sağlık profesyoneline başvurulmalıdır. |







.webp)





.webp)

Kronik kabızlık gerçekten önemli bir sağlık sorunu, bu durumu yaşıyor olmak oldukça zorlayıcı olabilir. Dışkılama sıklığımın ciddi şekilde azaldığını ve dışkımaların sert olduğunu duyduğumda, bunun ciddiyetinin farkına vardım. Uzun süreli kabızlık, bağırsak tıkanıklığı gibi ciddi problemlere yol açabilir, bu yüzden erken tedavi almak çok önemli. Öncelikle, bir doktora danışarak gerekli testleri yaptırmak iyi bir başlangıç olacaktır. Gaita ve kan testleri gibi tetkikler, sorunun kaynağını belirlemek için faydalı olabilir. Ayrıca, beslenme alışkanlıklarımda değişiklik yapmayı düşünüyorum; lif açısından zengin gıdalar tüketmeye ve yeterli sıvı almaya özen göstereceğim. Tedavi sürecinin bir parçası olarak düzenli egzersiz yapmayı da ihmal etmemek gerektiğini düşünüyorum. Bu sürecin benim için nasıl ilerleyeceğini merak ediyorum; umarım en kısa zamanda rahatlama sağlayabilirim.
Kronik Kabızlık ve Sağlık Sorunları
Traje, kronik kabızlık gerçekten önemli bir sağlık sorunu ve yaşadıklarının zorlayıcı olduğunu anlıyorum. Dışkılama sıklığındaki azalma ve sert dışkılama, ciddiyetine dikkat çekiyor. Uzun süreli kabızlık, gerçekten de bağırsak tıkanıklığı gibi ciddi problemlere yol açabilir. Bu nedenle, tedavi sürecine zamanında başlamak çok önemli.
Doktor Danışmanlığı
Bir doktora danışarak gerekli testleri yaptırmak, doğru tanı ve tedavi için ilk adım olacaktır. Gaita ve kan testleri, sorunun kaynağını belirlemede yardımcı olabilir. Bu süreçte doktorun önerilerine dikkat etmek, daha sağlıklı bir yaşam için önemlidir.
Beslenme Alışkanlıkları
Beslenme alışkanlıklarında yapacağın değişiklikler, kabızlık sorununu hafifletebilir. Lif açısından zengin gıdalar tüketmek ve yeterli sıvı almak, bağırsak sağlığını destekleyecektir. Bu değişiklikleri günlük rutininin bir parçası haline getirmek faydalı olacaktır.
Egzersiz ve Rahatlama Süreci
Düzenli egzersiz yapmak da önemli bir faktör. Fiziksel aktivite, sindirim sisteminin düzenli çalışmasına yardımcı olur. Bu süreçte sabırlı olman ve kendine zaman tanıman gerekebilir. Umarım en kısa zamanda rahatlama sağlayabilir ve sağlığına kavuşabilirsin. Geçmiş olsun!
Kronik kabızlık yaşıyorum ve dışkılama sıklığım ciddi şekilde azaldı. Ayrıca dışkı çok sert ve zor çıkıyor. Bu durumun tedavi edilmezse ciddi sağlık problemlerine yol açabileceğini okudum, doğru mu? Tedaviye nasıl başlamalıyım ve hangi testler yapılmalıdır?
İftihar, kronik kabızlık ciddi sağlık problemlerine yol açabilecek bir durumdur ve mutlaka tedavi edilmesi gerekmektedir. Kabızlık, bağırsak hareketlerinin yavaşlaması sonucu dışkının sertleşmesi ve zor dışkılama ile karakterizedir. Bu durum uzun süre devam ederse, hemoroid, anal fissür, divertikülit gibi komplikasyonlara ve hatta bağırsak tıkanmasına neden olabilir.
Tedaviye başlamak için öncelikle bir hekime başvurmanız gerekmektedir. Doktorunuz, sağlık geçmişinizi ve semptomlarınızı değerlendirerek uygun tedaviye yöneltecektir. Yapılabilecek testler arasında kan testi, tiroid fonksiyon testleri, kolonoskobi, röntgen ve bazen rektal muayene bulunabilir.
Ayrıca, beslenme ve yaşam tarzınızda yapacağınız değişiklikler de önemlidir. Bol lifli gıdalar tüketmek, yeterli miktarda su içmek ve düzenli egzersiz yapmak kabızlığı önlemeye yardımcı olabilir. Doktorunuzun önereceği ilaçlar veya laksatifler de tedavinizin bir parçası olabilir. Unutmayın, önemli olan bu durumu ihmal etmemek ve zamanında uygun tedaviye başlamaktır.